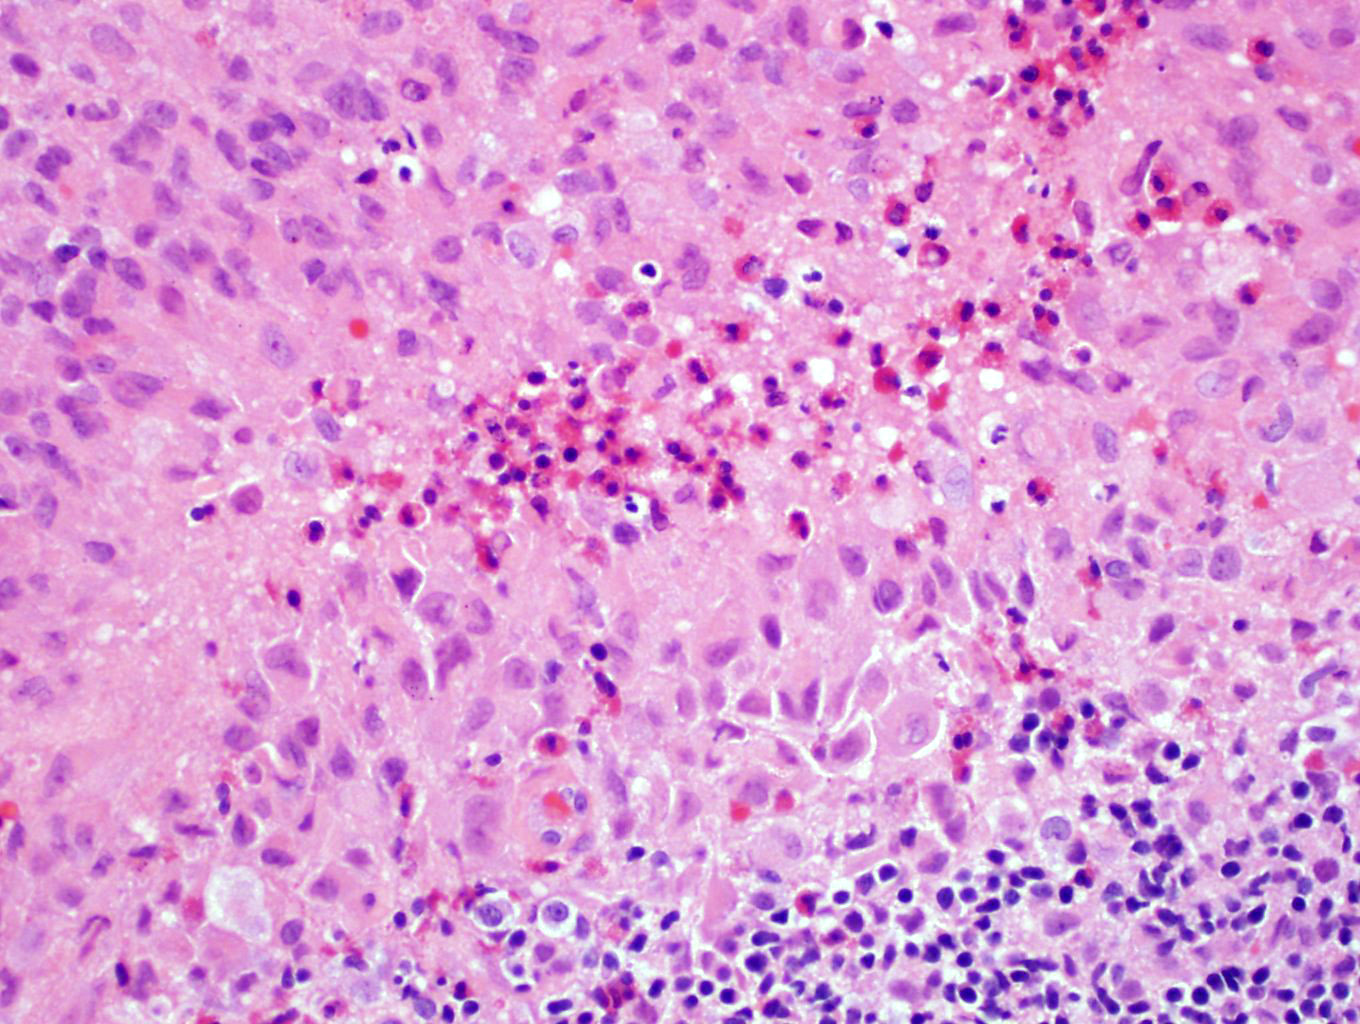

Table of Contents
Definition / general | Essential features | Terminology | ICD coding | Epidemiology | Sites | Pathophysiology | Etiology | Diagrams / tables | Diagnosis | Laboratory | Radiology description | Radiology images | Prognostic factors | Case reports | Treatment | Microscopic (histologic) description | Microscopic (histologic) images | Cytology images | Positive stains | Negative stains | Electron microscopy description | Electron microscopy images | Molecular / cytogenetics description | Sample pathology report | Differential diagnosis | Additional references | Board review style question #1 | Board review style answer #1 | Board review style question #2 | Board review style answer #2Cite this page: Shanmugam V, Pozdnyakova O. Langerhans cell histiocytosis. PathologyOutlines.com website. https://www.pathologyoutlines.com/topic/lymphnodesLCH.html. Accessed April 26th, 2024.
Definition / general
- Langerhans cell histiocytosis (LCH) is a clonal proliferation of cells that morphologically and immunophenotypically resemble Langerhans cells
Essential features
- Langerhans cell histiocytosis is a clonal proliferation of cells that morphologically and immunophenotypically resemble Langerhans cells
- More common in childhood (1 - 3 years old) and involves nodal and extranodal sites (most common site is bone)
- Lesional cells show prominent nuclear grooves with admixed eosinophils and are positive for CD1a, langerin (CD207) and S100
- Most cases harbor BRAF V600E mutations and other RAS / MAPK pathway activating mutations (Blood 2010;116:1919)
- Unifocal disease is generally associated with a good prognosis, whereas multisystem and multifocal disease is associated with poor prognosis
Terminology
- Histiocytosis X
- Eosinophilic granuloma (solitary bone lesion)
- Hand-Schüller-Christian disease (multiple lesions)
- Hashimoto-Pritzker disease
- Letterer-Siwe disease (disseminated or visceral involvement)
ICD coding
Epidemiology
- More common in childhood (1 - 3 years old)
- Incidence: 3 - 5 per million children, 1 - 2 per million adults (Blood 2015;126:26)
- M > F
- Pulmonary Langerhans cell histiocytosis strongly associated with smoking
Sites
- Can be unifocal, multifocal but involving a single organ system or involve multiple organs (Blood 2015;126:26)
- The most common sites involved are bone and adjacent soft tissue
- The following sites can also be involved, particularly in multisystem disease (in order of decreasing frequency): bone, skin, bone marrow, lymph nodes, liver, spleen, oral mucosa, lung, central nervous system / pituitary and gastrointestinal tract
- Brain involvement can result in a neurodegenerative syndrome; pituitary involvement can present with diabetes insipidus (Brain 2005;128:829)
Pathophysiology
- The majority of cases are clonal and harbor driver mutations involving the RAS / MAPK pathway (Blood 2010;116:1919)
- Misguided myeloid / dendritic cell model
- Clinical severity and distribution of Langerhans cell histiocytosis lesion(s) may be defined by the cellular stage of myeloid differentiation during which the somatic BRAF V600E or other activating kinase mutation arises and results in pathological extracellular signal regulated kinases (ERK) activation (Br J Haematol 2015;169:3)
Etiology
- Pulmonary Langerhans cell histiocytosis is strongly associated with smoking (N Engl J Med 2002;346:484)
- Causes for other forms are unknown
Diagnosis
- Imaging studies (Blood 2015;126:26):
- Skeletal survey
- PET-CT scan
- MRI: most effective for brain lesions
- Bone marrow biopsy / aspiration in patients with cytopenias
- Endoscopy to rule out gastrointestinal involvement in patients with evidence of malabsorption
- Biopsy of lesion(s): complete excision is not required, particularly for bone lesions
Laboratory
- Complete blood count: cytopenias suggest bone marrow involvement (Blood 2015;126:26)
- Liver function studies: abnormal if liver involved
Radiology description
- Plain radiographs / CT: solitary or multiple punched out lytic lesions without sclerotic rim
- MRI: T1 hypointense to isointense, T2 hyperintense, T1 contrast enhancing (Dähnert: Radiology Review Manual, 6th Edition, 2007)
Radiology images
Prognostic factors
- Localized (single system) disease: good outcome
- Multiorgan (2 or more organs) or multisystem disease including liver, spleen or bone marrow: poor outcome (Blood 2015;126:26)
Case reports
- 2 year old boy with generalized lymphadenopathy, hepatosplenomegaly and lytic lesions (J Cancer Res Ther 2015;11:1028)
- 7 year old girl with cervical lymphadenopathy (AABS 2016:3:C79)
- 41 year old woman with skin lesions and generalized lymphadenopathy (Postepy Dermatol Alergol 2015;32:225)
- 52 year old woman with inguinal lymphadenopathy (J Clin Pathol 2005;58:104)
- 68 year old woman with small lymphocytic lymphoma / chronic lymphocytic leukemia and rapidly expanding inguinal node (Case #314)
Treatment
- Surgical resection may be sufficient for single system disease (Blood 2015;126:26)
- Curettage may be sufficient for isolated bone lesions
- Systemic chemotherapy (vinblastine, prednisone, mercaptopurine)
- Smoking cessation for pulmonary Langerhans cell histiocytosis
Microscopic (histologic) description
- Partial effacement of lymph node with preservation of follicular centers
- Infiltration of sinuses by Langerhans cells: 12 - 15 microns in diameter with abundant, pale eosinophilic cytoplasm, irregular and elongated nuclei with prominent nuclear grooves and folds, fine chromatin and indistinct nucleoli (Arch Pathol Lab Med 2015;139:1211)
- Occasionally multinucleated
- Sinuses commonly have foci of necrosis, often surrounded by rim of eosinophils
- Variable mitotic activity
Microscopic (histologic) images
Contributed by Vignesh Shanmugam, M.D.
Contributed by Catherine Hagen, M.D.
AFIP images
Case #314
Cytology images
Positive stains
- CD1a (Histopathology 2002;41:1)
- Langerin (Histopathology 2002;41:1)
- S100 (Histopathology 2002;41:1)
- CD68 (Histopathology 2002;41:1, Blood 2001;97:1241, Mod Pathol 2010;23:1616)
- BRAF VE1 (~50% of cases) (Hematol Oncol 2018;36:307)
- CD45 (Histopathology 2002;41:1)
- CD4 (Histopathology 2002;41:1)
- Fascin (Am J Clin Pathol 2002;118:335)
- Cyclin D1 (Am J Surg Pathol 2017;41:1390)
Negative stains
- CD21 (Histopathology 2002;41:1)
- CD30 (Histopathology 2002;41:1)
- B and T lineage markers (except CD4) (Histopathology 2002;41:1)
Electron microscopy description
- Birbeck granules: tennis racquet shaped, 200 - 400 nm long and 33 nm wide, with a zipper-like appearance (Mol Biol Cell 2002;13:317)
Electron microscopy images
Molecular / cytogenetics description
- ~50% of cases harbor BRAF V600E mutations (Blood 2010;116:1919)
- ~35% of BRAF wild type cases show other activating mutations involving the MAPK pathway in a mutually exclusive manner (MAP2K1 mutations, BRAF fusions, ARAF mutations, ERBB3 mutations) (Blood 2016;128:2533, Blood 2014;124:3007, Blood 2014;123:3152, Blood 2014;124:1655)
- Most cases do not show any cytogenetic abnormalities (Genes Chromosom Cancer 2009;48:239)
Sample pathology report
- Lymph node, right inguinal, excisional biopsy:
- Langerhans cell histiocytosis (see comment)
- Comment: The sections show lymph node tissue with an infiltrate of epithelioid cells involving the interfollicular areas and sinuses. The infiltrate is composed of cells with irregular to folded nuclei with prominent nuclear grooves, vesicular chromatin, distinct nucleoli and moderate amounts of pale eosinophilic cytoplasm. Frequent admixed eosinophils are seen. Reactive appearing germinal centers are relatively preserved.
- Immunohistochemical studies demonstrate that the lesional cells are strongly positive for CD1a, langerin, S100 and cyclin D1.
Differential diagnosis
- Dermatopathic change:
- Pigment laden macrophages, lacks eosinophils, CD1a+ dendritic cells that are cyclin D1- (Am J Surg Pathol 2017;41:1390)
- Cat scratch disease:
- Granulomas with necrosis
- Kimura disease:
- Lacks a significant population of Langerhans cells
- Juvenile xanthogranuloma:
- Erdheim-Chester disease:
- Rosai-Dorfman disease:
- Langerhans cell sarcoma:
- Pleomorphic and highly atypical Langerhans cells
Additional references
Board review style question #1
Board review style answer #1
B. BRAF. The image shows histiocytoid cells in a background of eosinophils and multinucleated cells characteristic of Langerhans cell histiocytosis. The most frequent driver mutation in Langerhans cell histiocytosis is the BRAF V600E mutation (50% of cases).
Comment Here
Reference: Langerhans cell histiocytosis
Comment Here
Reference: Langerhans cell histiocytosis
Board review style question #2
A 2 year old boy presents with generalized lymphadenopathy, hepatosplenomegaly and lytic bone lesions. A diagnostic lymph node biopsy is performed which shows a sinusoidal infiltrate. Electron microscopy reveals club shaped structures in the lesional cells. Which of the following clinical findings can be seen in this entity?
- Bilateral sclerotic long bone lesions
- Elevated white blood cell count
- Hairy kidney
- Neurodegeneration
- Serum monoclonal paraprotein
Board review style answer #2
D. Neurodegeneration. The clinical scenario describes an aggressive presentation of multisystem Langerhans cell histiocytosis in a young patient. The histologic findings are characterized by sinusoidal involvement and electron microscopy shows Birbeck granules, i.e. club shaped or tennis racquet shaped structures in the neoplastic Langerhans cells. Brain involvement by Langerhans cell histiocytosis can result in neurodegenerative syndrome or diabetes insipidus secondary to involvement of the hypothalamic pituitary axis. Hairy kidney and sclerotic bone lesions are characteristic of Erdheim-Chester disease. Serum monoclonal paraproteins are typically seen in association with B cell lymphomas and plasma cell neoplasms.
Comment Here
Reference: Langerhans cell histiocytosis
Comment Here
Reference: Langerhans cell histiocytosis